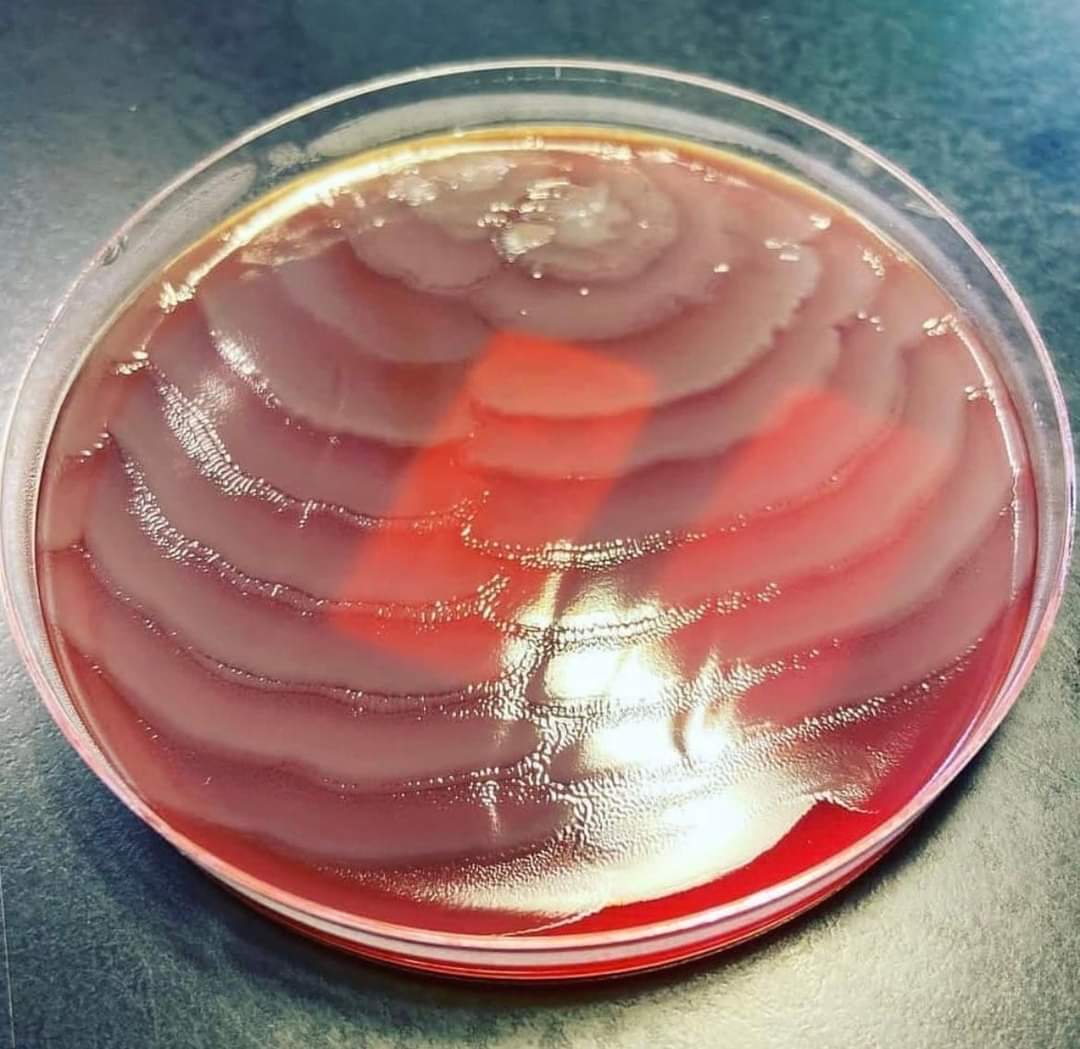
El fenómeno de "swarming" se caracteriza por la formación de círculos concéntricos a partir del punto de inoculación, que le brindan un aspecto de diana a la colonia. 

Lo más sorprendente de este fenómeno ocurre a nivel microscópico, cuando los bacilos, que provienen de un medio
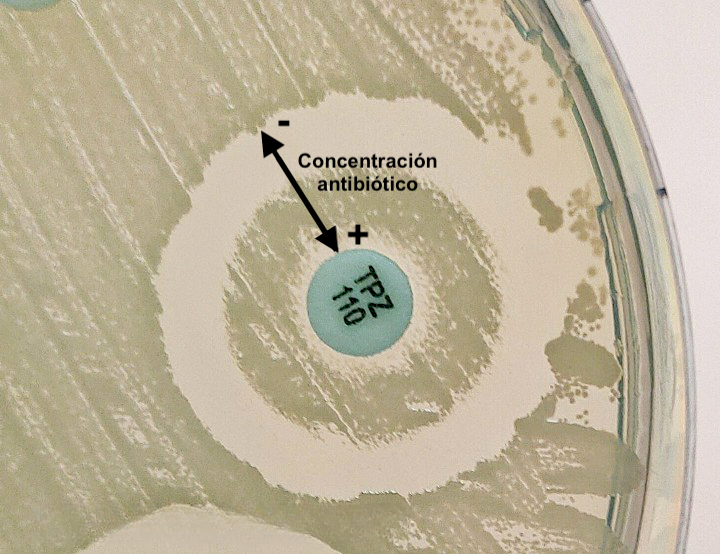
👁️OJO:
Como se denomina este efecto "paradójico", descrito en 1948 por Harry ....., en el que la eficacia de un antibiótico💊 disminuye a medida que aumenta la concentración del fármaco?

Begoña Martin
@begomafe
PhD Pharmacy (UCM) & Chemistry (UNED). Farmacéutica de amplio espectro: Salud, Ciencia, Marketing, AMR. Miembro @JuntosXTuSalud. Solo opiniones personales
ID: 448032679
27-12-2011 14:56:06
2,2K Tweet
6,6K Followers
5,5K Following








The WHO AWaRe (Access, Watch, Reserve) antibiotic book es un recurso de referencia para el uso adecuado de antimicrobianos (elección, dosis, vía, duración...) 📘Libro World Health Organization (WHO) who.int/publications/i… 📱App Firstline firstline.org/who/ 🎨Infografías who.int/publications/i…




Broncoaspirado de paciente con enfermedad pulmonar crónica y bronquiectasias, observada al 🔬 con 3 métodos distintos. ¿🦠? ¿Cuáles son las técnicas del 🔬 y cuáles son sus ventajas? Felipe Pérez-García, PhD Jose Sanchez